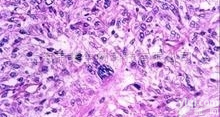
ST<em>细胞</em>  猪<em>睾丸</em><em>细胞</em>系，ST<em>细胞</em>

Hs 1.Tes细胞, 正常人睾丸细胞
- 产地:中国大陆
- 供应商:上海锐聪实验室设备有限公司
- 供应商报价:电议
- 标签:Hs 1.Tes细胞, 正常人睾丸细胞 ,生命科学,细胞分析,供应Hs 1.Tes细胞, 正常人睾丸细胞 ,上海锐聪实验室设备有限公司
Hs 1.Tes细胞, 正常人睾丸细胞 免费运输,保证运输中细胞的正常生长,关于其价格、报价、货期,请咨询我们。
产品特点:活性好、存活率高、实验成果特征明显
产品来源:人组织、小鼠组织、大鼠组织、兔组织等动物组织
产品运输:免费快递
产品包装:瓶装
产品用途:细胞培养研究
Hut-102细胞, 人T淋巴瘤细胞系
MCF-7细胞, 人乳腺癌细胞系
ZR-75-30细胞, 人乳腺癌细胞系
PK-15细胞, 猪肾细胞系
IBRS-2细胞, 猪肾细胞系
ST细胞, 猪睾丸细胞系
Sf-21细胞, 昆虫细胞系
SF-9细胞, 昆虫细胞系
L8824细胞, 草鱼肝脏细胞
CIK细胞, 草鱼肾脏细胞
WCF细胞, 团头鲂尾鳍细胞
SCF细胞, 白鲢尾鳍细胞
SiHa细胞, 人宫颈鳞状细胞癌
Ski细胞, 人宫颈上皮细胞癌
SW626细胞, 人卵巢腺癌细胞
BI U-87细胞, 膀胱癌细胞
C6/36细胞, 蚊子细胞
HBZY-1细胞, 大鼠肾小球系膜细胞
AN3 CA细胞, 人子宫内膜腺癌细胞
H4细胞, 人脑神经胶质瘤细胞
Hs 1.Tes细胞, 正常人睾丸细胞 其它半价、放价、低价公司产品:
大鼠胱天蛋白酶9(Casp-9)ELISA试剂盒 Rat Caspase-9,Casp-9 ELISA试剂盒 96T/48T
大鼠阿立新A(Orexin A)ELISA试剂盒 Rat Orexin A ELISA试剂盒 96T/48T
大鼠胱天蛋白酶3(Casp-3)ELISA试剂盒 Rat Caspase 3,Casp-3 ELISA试剂盒 96T/48T
大鼠B细胞淋巴瘤因子2(Bcl-2)ELISA试剂盒 Rat B-cell leukemia/lymphoma 2,Bcl-2 ELISA试剂盒 96T/48T
大鼠CXC趋化因子受体3(CXCR3)ELISA试剂盒 Rat CXC-chemokine receptor 3,CXCR3 ELISA试剂盒 96T/48T
大鼠中性粒细胞弹性蛋白酶(NE)ELISA试剂盒 Rat neutrophil elastase,NE ELISA试剂盒 96T/48T
大鼠肿瘤特异生长因子/肿瘤相关因子(TGSF)ELISA试剂盒 Rat Tumor Specific Growth Facter/tumor supplied group of factor,TGSF ELISA试剂盒 96T/48T
大鼠羟脯氨酸(Hyp)ELISA试剂盒 Rat hydroxyproline,Hyp ELISA试剂盒 96T/48T
大鼠骨保护素配体(OPGL)ELISA试剂盒 Rat Osteoprotegerin Ligand,OPGL ELISA试剂盒 96T/48T
大鼠乳铁传递蛋白/乳铁蛋白(LF/LTF)ELISA试剂盒 Rat Lactoferrin,LTF/LF ELISA试剂盒 96T/48T
大鼠抗肌内膜抗体IgA(EMA IgA)ELISA试剂盒 Rat anti-Endomysial Antibody IgA,EMA IgA ELISA试剂盒 96T/48T
大鼠铁蛋白(FE)ELISA试剂盒 Rat ferritin,FE ELISA试剂盒 96T/48T
大鼠碳酸酐酶2(CA-2)ELISA试剂盒 Rat carbonic anhydrase 2,CA-2 ELISA试剂盒 96T/48T
大鼠色素上皮衍生因子(PEDF)ELISA试剂盒 Rat pigment epithelium-derived factor,PEDF ELISA试剂盒 96T/48T
大鼠解整合素样金属蛋白酶8(ADAM8)ELISA试剂盒 Rat A Disintegrin And Metalloprotease 8,ADAM8 ELISA试剂盒 96T/48T
大鼠抗胰蛋白酶(AT)ELISA试剂盒 Rat Anti-trypsin,AT ELISA试剂盒 96T/48T
大鼠胰岛细胞抗体(ICA)ELISA试剂盒 Rat islet cell antibody,ICA ELISA试剂盒 96T/48T
大鼠肾损伤分子1(Kim-1)ELISA试剂盒 Rat Kidney injury molecule 1,Kim-1 ELISA试剂盒 96T/48T
大鼠抗单核细胞抗体(AMA)ELISA试剂盒 Rat anti-Monocyte antibody,AMA ELISA试剂盒 96T/48T
大鼠氧化低密度脂蛋白抗体(OLAb)ELISA试剂盒 Rat oxidized lowdensity lipoprotein antibody,OLAb ELISA试剂盒 96T/48T
大鼠抗平滑肌抗体(ASMA)ELISA试剂盒 Rat Anti-Smooth Muscle Antibody,ASMA ELISA试剂盒 96T/48T
大鼠核因子κB亚基p65亲和肽(NF-κB p65)ELISA试剂盒 Rat nuclear factor-κB p65,NF-κB p65 ELISA试剂盒 96T/48T
大鼠纤溶YZ因子/凝血酶激活的纤溶YZ物(TAFI)ELISA试剂盒 Rat Thrombin activatable fibrinolysis inhibitor,TAFI ELISA试剂盒 96T/48T
大鼠血小板膜糖蛋白ⅡbⅢa(GP-ⅡbⅢa/CD41+CD61)ELISA试剂盒 Rat platelet membrane glycoprotein ⅡbⅢa,GP-ⅡbⅢa ELISA试剂盒 96T/48T
大鼠游离脂肪酸(FFA)ELISA试剂盒 Rat free fatty acids,FFA ELISA试剂盒 96T/48T
大鼠血小板反应蛋白/凝血酶敏感蛋白1(TSP-1)ELISA试剂盒 Rat thrombospondin 1,TSP-1 ELISA试剂盒 96T/48T
大鼠骨粘连蛋白(ON)ELISA试剂盒 Rat osteonectin,ON ELISA试剂盒 96T/48T
大鼠叶酸(FA)ELISA试剂盒 Rat Folic acid,FA ELISA试剂盒 96T/48T
大鼠组蛋白H2b(histon-H2b)ELISA试剂盒 Rat histon-H2b ELISA试剂盒 96T/48T
大鼠N端前脑钠素(NT-proBNP)ELISA试剂盒 Rat N-terminal pro-brain natriuretic peptide,NT-proBNP ELISA试剂盒 96T/48T
大鼠糖皮质类固醇受体(GR)ELISA试剂盒 Rat glucocorticoid receptor,GR ELISA试剂盒 96T/48T
大鼠黄体生成素释放激素(LHRH)ELISA试剂盒 Rat Luteinizing Hormone-Releasing Hormone,LHRH ELISA试剂盒 96T/48T
大鼠8异前列腺素(8-iso-PG)ELISA试剂盒 Rat 8-iso prostaglandin,8-iso-PG ELISA试剂盒 96T/48T
大鼠γ干扰素诱导蛋白16/p16(IFI16/p16)ELISA试剂盒 Rat interferon-inducible protein 16,IFI16/p16 ELISA试剂盒 96T/48T
大鼠基质细胞衍生因子1a(SDF-1a/CXCL12)ELISA试剂盒 Rat Stromal cell derived factor 1a,SDF-1a ELISA试剂盒 96T/48T
大鼠血浆α颗粒膜蛋白(GMP-140)ELISA试剂盒 Rat alpha-granular membrane protein,GMP-140 ELISA试剂盒 96T/48T
大鼠髓过氧化物酶(MPO)ELISA试剂盒 Rat myeloperoxidase,MPO ELISA试剂盒 96T/48T
大鼠颗粒酶B(Gzms-B)ELISA试剂盒 Rat granzymes B,Gzms-B ELISA试剂盒 96T/48T
大鼠颗粒酶A(Gzms-A)ELISA试剂盒 Rat granzymes A,Gzms-A ELISA试剂盒 96T/48T
大鼠淋巴细胞趋化因子(Lptn/LTN/XCL1)ELISA试剂盒 Rat lymphotactin,Lptn/LTN ELISA试剂盒 96T/48T
大鼠末端补体复合物C5b-9(TCC C5b-9)ELISA试剂盒 Rat terminal complement complex C5b-9,TCC C5b-9 ELISA试剂盒 96T/48T
大鼠补体蛋白4(C4)ELISA试剂盒 Rat Complement 4,C4 ELISA试剂盒 96T/48T
大鼠肾素(Renin)ELISA试剂盒 Rat Renin ELISA试剂盒 96T/48T
大鼠膜联蛋白Ⅴ(ANX-Ⅴ)ELISA试剂盒 Rat annexin Ⅴ,ANX-Ⅴ ELISA试剂盒 96T/48T
大鼠抗内皮细胞抗体(AECA)ELISA试剂盒 Rat anti-endothelial cell antibody,AECA ELISA试剂盒 96T/48T
大鼠全段甲状旁腺素(i-PTH)ELISA试剂盒 Rat intact Parathormone ,i-PTH ELISA试剂盒 96T/48T
大鼠牛小肠碱性磷酸酶(CIAP)ELISA试剂盒 Rat Calf Intestine Alkaline Phosphatase,CIAP ELISA试剂盒 96T/48T
大鼠肺表面活性物质相关蛋白A(SP-A)ELISA试剂盒 associated protein Hs 1.Tes细胞, 正常人睾丸细胞 A,SP-A ELISA试剂盒 96T/48T
大鼠克拉拉细胞蛋白(CC16) ELISA试剂盒 Rat Clara cell protein,CC16 ELISA试剂盒 96T/48T
大鼠肾上腺素(EPI)ELISA试剂盒 Rat Epinephrine/Adrenaline,EPI ELISA试剂盒 96T/48T

![[<em>细胞</em>及相关培养] ATCC引进<em>细胞</em> Hs 181.Tes(<em>正常人</em><em>睾丸</em><em>细胞</em>)](https://item.yiqi.com/pic/CovPic/1/201082593112782.jpg)